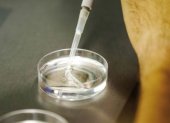
.

Coronavirus: Los retos pendientes para volver a la cancha
Roberto Villavicencio, Modesto García
La LigaPro y los equipos deben ejecutar con eficiencia los protocolos sanitarios, definir el sistema de juego y evitar afectaciones económicas

Roberto Villavicencio, Modesto García
La LigaPro y los equipos deben ejecutar con eficiencia los protocolos sanitarios, definir el sistema de juego y evitar afectaciones económicas

Juan Ponce Merchán
Las terapias se realizan con medidas de seguridad y llegan hasta sus casas. Residentes tienen contacto con sus familiares a través de redes sociales.

Gilson Pinargote
Este hallazgo podría explicar la alta prevalencia del coronavirus en las residencias de mayores o centros de cuidados

Roberto Villavicencio
El técnico que fue campeón con Olmedo y D. Cuenca, y dirigió a Emelec, El Nacional, Liga de Quito, entre otros clubes, se fracturó la cadera y fémur

Mariella Toranzos
El análisis fue hecho en el marco de un proceso jurídico que data del año 2000.

Pamela Castillo
El pugilista, de 22 años, creció entre negocios ilícitos y pasillos de la cárcel. En junio peleará por el título nacional superpluma.
Gilson Pinargote
Expertos han logrado inyectar diminutos sensores dentro de óvulos vivos que permiten medir las fuerzas que se generan desde que entra el espermatozoide hasta que el embrión se divide en dos células

Alejandro Puga
La banda quiteña le sacó provecho a la cuarentena y finalizaron dos producciones musicales que ya tenían programadas para el 2020

Marieta Campaña
Diana Salazar lamentó que en las redes sociales se hayan generado una serie de comentarios llenos de violencia

Christian Flores
El país balcánico anunció que dará el primer gran paso que el mundo espera. El fútbol y el tenis encabezan la lista. Hay gran expectativa





Más visto